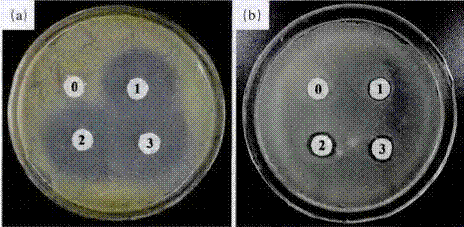
image008.gif

HBP-NH2原位生成沉积纳米Zn O整理棉织物研究Yd16401
张德锁 廖艳芬 林红 陈宇岳
作者简介:张德锁,男,1981年生,博士研究生,主要研究方向为纤维资源的开发利用及 陆技术。
通讯作者:林红,副教授,linhong523@suda.edu.cn
作者单位:苏州大学纺织与服装工程学院、现代丝绸国家工程实验室。
基金项目: 国家高技术研究发展计划项目(No.2012AA030313);江苏省高校自然科学基金项目(No.11KJB540002);苏州市社会发展支撑项目(No.zxs20120O8)。
原载:纺织导报2013/8;73-76
【摘要】本文利用端氨基超支化聚合物(HBP―NH:)与Zn(NO ):直接在水溶液中反应生成纳米ZnO沉积到棉织物中,以实现对棉织物的功能化整理,探讨了其机理,测试了整理后棉织物的抗菌和抗紫外性能,并对整理的棉织物进行了表征。结果表明:HBP―NH:具有多重作用,有助于纳米ZnO的制备和性能提升;整理后的棉织物具有优异的抗紫外性能和一定的抗菌性能,并且其UPF值和抑菌率都随着ZnO含量的增加而上升。
【关键词】超支化聚合物;纳米氧化锌;棉织物;抗紫外;抗菌性
【中图分类号】TSI95.6 文献标志码:A
超支化聚合物由于其丰富的末端官能团、近似球形的三维立体结构、内部大量的空腔、高溶解性、低粘度、高反应活性等物理、化学特征,在涂料工业、流变学改性剂、纳米技术等多个领域有着广泛的应用前景。基于超支化聚合物内部的空腔结构,利用其作为模板可以有效控制制备纳米材料。目前,已有利用超支化聚合物控制制备纳米银、纳米金、纳米ZnO、纳米铂、纳米二氧化锡等纳米材料的研究报道。
前期研究中,本课题组自主设计合成制备了一种以氨基为端基的超支化聚合物(HBP-NH2),并利用其控制制备纳米银,应用于棉织物的抗菌整理。由于HBP-NH2中丰富的氨基,其在水溶液中易质子化显碱性,能够与锌盐在水热的条件下直接反应生成ZnO。同时,由于超支化聚合物的控制、保护作用,有望能够形成纳米级的ZnO颗粒。本文利用
HBP-NH2和Zn(NO3)2为原料,在水溶液中直接生成、沉积纳米ZnO到棉织物中,以实现对棉织物的整理。探讨了整理机理,测试了整理后棉织物的抗菌和抗紫外性能,并对整理的棉织物进行了表征。
1 实验部分
1.1 材料与仪器
实验材料:HBP-NH2(Mn=2 684,Mw=7 759,实验室自制)、六水合硝酸锌(分析纯)、氯化钾(分析纯)、浓硝酸(65%);纯棉漂白布(120 g/m 2);金黄色葡萄球菌(S.aureus)ATCC6538、大肠杆菌(E.coli)ATCC8099,苏州大学生命科学学院提供;营养琼脂培养基(NA)、营养肉汤培养基(NB),上海中科昆虫生物技术开发有限公司。
实验仪器:Nano-SZ90型Zeta电位仪(英国Malvern公司);UV-1000F型紫外线透过率仪(美国Labsphere公司);S4800型扫描电子显微镜(日本Hitachi公司);电感耦合等离子体发射光谱仪(美国Varian公司);X’pert pro型X射线衍射仪(荷兰Philips公司)。
1.2 实验方法
1.2.1 原位生成沉积纳米ZnO整理棉织物
分别将HBP-NH2和Zn(NO3)2溶于去离子水中配制成浓度分别为100 g/L和1 mol/L的母液,根据反应浓度需要将一定量的HBP-NH2母液加到去离千水中,然后在室温下滴加一
定量的Zn(NO3)2溶液,并不断搅拌。将棉织物浸入上述混合溶液中(浴比1:50),持续搅拌30 min后加热至沸腾,溶液变浑浊,待溶液冷却后取出织物80℃烘干,150℃焙烘3min,水洗去除浮于表面的ZnO,然后烘干备用。
1.2.2 棉织物Zeta电位测定
将棉织物剪成细小粉未状,用l mmol/L氯化钾水溶液将其配制成0.05%的溶液,然后调节至不同pH值,超声波搅拌10 min,用Zeta电位仪测定其Zeta电位。
1.2.3棉织物表征
(1)SEM分析:利用扫描电子显微镜(SEM)对未处理和经原位生成沉机纳米ZnO整理的棉织物纤维表面微观形貌进行观察。
(2)元素组成分析:在进行SEM测试时,利用其DEX附件对整理的棉织物表面元素进行扫描分析。
(3)XRD分析:未整理的棉织物和经纳米ZnO整理后的棉织物利用x射线衍射仪在40 kV电压、30 mA电流条件下测定其结晶结构,并对比不同。扫描速度为5.0°/min,扫描范围2theta=IO°~80°。
(4)ZnO含量测试:将100 mg整理后的棉织物样品溶于10mL浓硝酸中,待其溶解后用去离于水稀释10倍至100mL;取一定量稀释后的溶液利用电感耦合等离子体发射光谱仪测定溶液中锌离子浓度。由此计算整理到棉织物中的纳米ZnO含量。
1.2.4 棉织物抗紫外性能测试
未整理和纳米ZnO整理的棉织物紫外线防护系数(UPF)以及相应的透过率曲线采用UV-1000F型紫外线透过率仪测定,选择测定标准为EN 13758-l:2001。
1.2.5 棉织物抗菌性能测试
经整理的棉织物抗菌性能分别通过抑菌圈定性试和抑菌率定量测试测定,试验菌种为革兰氏阳性菌金黄色葡萄球菌和革兰氏阴性菌大肠杆菌。抑菌率定量测试采用GB/T
20944.3-2008《纺织品抗菌性能的评价》中震荡烧瓶法进行,试样抑菌率计算公式如下:
|
Y= |
Wb-Wc |
×100% |
|
Wb |
式中:Y为抑菌率,%;Wb为空白样振荡接触18h后晓瓶内的活菌浓度。CFU/mL;Wc为待测织物试样振荡接触18h后烧瓶内的活菌浓度,CFU/mL。
2 结果与讨论
2.1 整理机理探讨
锌盐与碱(如NaOH)在热水中反应可以直接生成Zn0,井且具有较高的转化率,但所制备的ZnO颗粒较大,因此可以在制备过程中加入高聚物来控制成的ZnO的形貌和大小。超支化聚合物由于其独特的结构和性能,已在多种纳米材料的制备中表现出很好的调节控制作用。由于HBP-NH2中富含氨基,在水溶液中易质子化显碱性,因此其水溶液可以与锌盐直接反应制备ZnO。利用4g/L的HBP-NH2与24
mmol/L的Zn(NO3)2反应制备纳米ZnO.其反应前后溶液的pH值及生成的纳米ZnO的Zetat电位见表1。
|
表1反应前后溶液的pH值及生成的纳米ZnO的Zetat电位 |
|
||
|
反应前 |
反应后 |
Zeta电位 |
|
|
11.30 |
6.73 |
5l.6 |
|
从表l可以看出,在加入Zn(NO3)2前HBP-NH2溶液pH值为11.30,说明HBP-NH2中的氨基在水中质子化后释放出大量OH离子。当加入Zn(NO3)2并加热反应后,溶液降到中性附近,说明Zn2+与OH发生反应,消牦掉了溶液中的OH离子。同时,HBP-NH2会包裹在生成的ZnO表面,对其起控制作用,以制备具有较小粒径的纳米ZnO。由于HBP-NH2质子化后显正电性。所以聚合物中含有大量正电荷,其包裹控制的纳米ZnO也因此带有大量正电荷。
图l为不同pH值下棉纤维表面Zeta电位。
|
|
|
图1棉纤维表面Zeta电位 |
由图可见,在中性和碱性条件下棉纤维带负电。当将棉织物浸渍于反应液中加热反应生成纳米ZnO时,由于纳米
ZnO高的正电性和棉纤维的负电性,生成的纳米ZnO会主动沉积到棉织物中实现对棉织物的原位生成沉积整理。另外,在沉渍过程中HBP-NH2会携带Zn2+渗透到棉纤维内部,有望在纤维内部生成纳米ZnO实现对其的整理。
综上所述,HBP-NH2在原位生成沉积纳米ZnO整理棉织物时发挥了多重作用。其不仅能够充当反应试剂,与Zn(NO3)2反应生成纳米ZnO;还能够对生成的纳米ZnO起控制和保护作用;另外,其还能促使生成的纳米ZnO主动沉积到棉织物中,并提供纳米ZnO与棉纤维较强的吸附力。
2.2 整理棉织物抗紫外性能
在不同Zn(NO3)2和HBP-NH2浓度下整理的棉织物抗紫外性能及其ZnO含量见表2。
|
表2 整理棉织物中ZnO含量及其抗紫外性能 |
|
|
由表2可知,未整理的棉织物UPF仅为4.79,紫外线透过率很高,而经原位生成沉积纳米ZnO整理的棉织物均具有优异的抗紫外性能,且其UPF随着反应物浓度的增加迅速上
升,这是因为反应物浓度的提高,生成和沉积在棉织物上的纳米ZnO量迅速增加。同时,整理的棉织物UVA和UVB的透过率迅速下降,说明纳米ZnO能够起到很好的紫外线屏蔽作用。当Zn(NO3)2和HBP-NH2浓度分别为96 mmol/L和l6g/L时,整理制备的棉织物UPF值达到了135.93。
图2为表2中4个样品的紫外线透过率曲线图。
|
|
|
图2整理棉织物紫外线透过率曲线 |
由图2 可见,未整理的棉织物具有较高的紫外线透过率,经纳米ZnO整理的棉织物紫外线透过率迅速下降.特别是对人体伤害较大的UVB波段,因此经整理的棉织物能够有效阻隔紫外线,防止紫外线照射对人体的伤害。
2.3 整理棉织物抗菌性能
纳米Zn0不仅具有优异的紫外线屏蔽作用,由于其表面的氧空缺产生氧负离子,与水结合生成H2O2,因此,还能起到一定的抗菌效果。利用抑菌圈定性测试法和抑菌率定量测试法分别对表2
中不同浓度整理的棉织物(1~3号样)进行了抗菌性能测试,结粜如图3所示。
|
|
|
图3 纳米ZnO整理棉织物的抑菌圈 |
图3为纳米ZnO整理棉织物的抑菌圈图片,(a)中为金黄色葡萄球菌,(b)中为大肠杆菌。从中可以看出,未整理的棉织物周围长满细菌(0号样),没有明显的抑菌圈.而经纳米Zn0整理的棉织物周围有明显的抑菌圈。并且整理的棉织物对金黄色葡萄球菌的抑菌圈远大于对大畅杆菌的抑菌圈。蜕明纳米Zn0对金黄色葡萄球菌的抑菌性能大于大肠
杆菌。同时,从图3(b)可以看出,3个经处理的样品对大肠杆菌的抑菌圈有逐渐增大的趋势,说明随着织物中ZnO含量的增加,其抗菌性能提高。
上述经处理的3个样品的抑菌率数据见表3。
|
表3 纳米ZnO整理棉织物抑菌率 |
|
|
从表3中数据可以看出,3个样品对金黄色葡萄球菌都具有较好的抗菌效果,抑菌率均大于99.9%。样品l对大肠杆菌的抑菌率只有50.47%,说明纳米ZnO对金黄色葡萄球菌的抗菌效果明显优于对大肠杆菌的抗蔺效果,这和图3中抑菌圈实验的结果一致。随着ZnO含量的增加,其对大肠杆菌的抑菌率明显上升,当ZnO含量为3.5%时(样品3).对金黄色色葡萄球菌和大肠杆菌的抑菌率均在99%以上。
2.4 整理棉织物表征
为了观察原位生成沉积的纳米ZnO在棉织物表面的沉积和分布状态,利用SEM对其表面形貌进行了观察和电子能谱分析,结果分别如图4、图5所示。
|
|
|
图4未整理(a)和纳米ZnO整理(b)棉纤维的电镜图 |
从图4 可以看出,未整理的棉织物纤维表面除棉纤维本身特征沟槽外无任何杂质,表面相对光滑,而经原位生成沉积纳米ZnO整理的棉织物纤维上附着大量微小颗粒,H”即沉积在棉织物上的纳米ZnO。其粒径在80 nm左右。
图5为利用SEM对整理后棉织物进行扫描得到的EDX谱图,图中显示出很强的Zn和O的峰,其中Zn主要来源于表面附着的纳米ZnO,而O则来源于ZnO以及棉纤维。
|
|
|
图5 整理棉织物表面EDX谱图 |
图6为未整理和经纳米ZnO整理的棉织物的XRD谱。
|
|
|
图6未整理(a)和纳米ZnO整理(b)棉织物的XRD谱图 |
从图6可以看出,未整理的棉织物在14.81、16.46、22.71和34.2位置出现了4个衍射峰.分别对应于棉纤维纤维素I的(101)、(101)、(002)和(040)晶面的衍射。而整理后的棉织物除棉纤维的4个衍射峰外,在131.85、34.53、36.36、47.62、56.65、62.93和67.98位置还出现了另外7个衍射峰,分别对应于纤锌矿纳米ZnO的(100)、(002)、(101)、(102)、(110),(103)和(112)晶面的衍射,说明纳米ZnO被整理到棉织物中,并且具有较好的结晶性。
3 结论
(1)HBP-NH2水溶液可以与Zn(NO3)2直接反应生成纳米ZnO沉积到棉织物中实现对棉织物的功能化整理,在此过程中HBP-NH2具有多重作用,其不仅作为反应试剂制备纳米ZnO。还能对纳米ZnO的生成起控制作用,同时改变纳米ZnO表面带电性,使其能够主动吸附沉积到棉织物中。
(2)整理后的棉织物表面分布了大量粒径约80nm的纳米ZnO颗粒。
(3)利用HBP-NH2原位生成沉积纳米ZnO整理的棉织物有优异的抗紫外性能和一定的抗菌性能,当ZnO含量为3.5%时,其时金黄色葡萄球菌和大肠杆菌的抑菌率均高于99%。
参考文献
[l] Gao C,Yan
D.Hyperbranched polymers:from synthesis to applica tions [J].Progress in Polymer
Science.2004、29(3):183-275
[2] Saliba
S,Valverde S C.Keilitz J.et a1.Hyperbnmched polymers for the formation
and stabilization of Zn0 nanoparticles[J] Chemistry of Materials.2010.22(23):6301-6309
[3]
Juttukond V.Paddock R,Raymond J E.et al.Fatile synthesis of Tin oxide
nanoparticles stabilized by dendritic polymers[J].Journal of the American
Chemical Society.2006.128 (2)420-421
[4]Zhang
F.ChenYY,LinH,et al Synthesis of an amino-terminated
hyperbranched polymer and its application in reactive dyeing on cotton as a
salt-free dyeing auxiliary[J].Coloration Technology.2007,123(6}:351-357
[5] Zhang
F.Wu X L.Chen Y Y,et. al Application of silver nanoparticles to Cotton
fabric as an antibacterial textile finish[J].Fibers and Polymers.2009.10(4):496-501
[6] Jiang L,LiGC.JiQM.et.
a1.Morphological control of ,flower-like Zn0 nanosttuctures[J].Materials
Letters 2007.6l(10):1064-1967.
[7]WnC
L.QiaoX L,Chen JG.et al.A novel chemical toute to prepare Zn0
nanoparticles[J].Materials Letters.2006,60(15):1828-1832.
[8]HarunarRM,RaulaM,Bhanacharjee RR.et a1.Low-temperature polymer-assisted synthesis of
shape-tunable zinc oxide nanostructures dispersible in both aqueous and
non-aqueous media[J].Jonmal of Colloid and 1nterflace Science.2009,339 (1):249-258.
[9] Lin H,Yao
L R.Chen YY.et.a1.Structure and properties of silk Fibroin modified cotton
[J].Fibers and Polymers.2008,9(2):113-l20.
[10]
Sricharussin W.Threepopnatkul P. Neamjan N.Effect of various Shapes of zinc
oxide nanoparticles on colton fibric for UV-blocking and Anti-bacterial
properties;[J].fibers and polymers 2011,12(8):1037-1041.